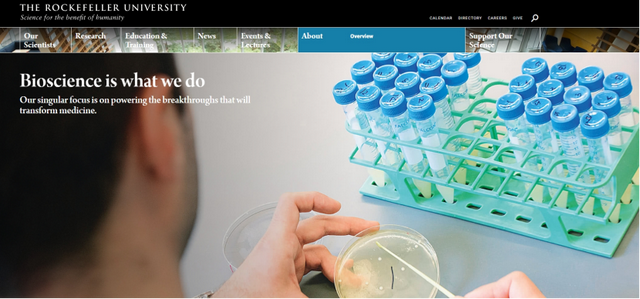

洛克菲勒大学(Rockefeller University,简称RU),是世界领先的生物医学研究大学,位于美国纽约曼哈顿。学校吸引了来自世界各地的顶尖科学家和研究生,在这里开展科学研究,造福人类。大学的起源部分源于个人悲剧。1901年1月,老约翰洛克菲勒的孙子死于猩红热,此后,这位资本家和慈善家制定了建立研究中心的计划,洛克菲勒研究所成为美国第一个生物医学研究中心。

1955年,洛克菲勒研究所将其使命扩展到教育领域,招收了第一批研究生。1959年,研究所授予了第一批博士学位。1965年,洛克菲勒研究所更名为洛克菲勒大学,进一步扩大了研究范围。洛克菲勒大学在积极致力于培养下一代科学家的同时,生物医学研究一直是学校的中心任务。

洛克菲勒大学是现代细胞生物学的起源地之一。在这里,科学家首次发现血型,DNA是一种遗传物质,以及病毒可导致癌症。20世纪许多重要的科学突破诞生于这所学校的实验室。洛克菲勒大学教师的成就在学术界几乎是无与伦比的。在大学的历史上,教师们共获得过26项诺贝尔奖和26项Albert Lasker奖,以及其他享有盛誉的荣誉。

洛克菲勒大学无官方院系划分,开设的72个实验室引领着生物科学领域的突破,解决世界上最紧迫的科学难题和健康问题。研究包含了10个广泛领域:生物化学、生物物理学、化学生物学和结构生物学;癌症生物学;细胞生物学;遗传学与基因组学;免疫学、病毒学和微生物学;人类疾病的机理;神经科学与行为学;有机体生物学与进化;物理、数学和计算生物学;干细胞、发育、再生和衰老。

洛克菲勒大学专注于生物医学和生命科学领域,不属于综合大学,所以并未登上U.S.News、TIMES等世界大学综合排名的榜单。但其在U.S.News研究生学院的专业排名上表现非常优异:生物科学排名第17位;生物化学/生物物理学/结构生物学排名第9位;细胞生物学排名第5位;分子生物学排名第8位:神经科学/神经生物学排名第11位;化学排名第46位;生物化学排名第12位。

洛克菲勒大学高度灵活的研究生培训计划旨在培养和激励未来的科学领袖。学校的实验室是学生体验的中心。大学具体开设的生物科学研究生课程/项目为:临床研究培训计划Clinical Research Training Programs、洛克菲勒大学科学拓展RockEDU Science Outreach、博士后项目Postdoctoral Programs、本科生项目Undergraduate Programs。

洛克菲勒大学提供全美顶尖的医学博士/哲学博士课程(M.D./Ph.D.),与邻近的纪念斯隆凯特琳癌症中心和威尔康奈尔医学中心合作,开设了领先的化学生物学博士课程(chemical biology Ph.D. program )。洛克菲勒大学的学生享受全额资助,住在曼哈顿上东区的高补贴住房中,学费为零。

洛克菲勒大学致力让博士后研究人员充分参与社区科学、教育和文化活动。200多名博士后与洛克菲勒实验室的研究工作相关联,在这里接受科学培训,追求自己的研究兴趣。此外,博士后研究人员还参加学校和纽约市举办的研讨会、专题讨论会。博士后职位的候选人会从私人或政府资助机构获得资金。

洛克菲勒大学生物科学研究生项目:
戴维洛克菲勒生物科学研究生项目The David Rockefeller Graduate Program in Bioscience
戴维洛克菲勒生物科学研究生项目The David Rockefeller Graduate Program in Bioscience是世界闻名的研究生项目,开设生物医学科学biomedical sciences、化学chemistry、生物物理学biophysics领域,进行研究和研究生教育的机会。

戴维洛克菲勒生物科学研究生项目提供一系列精选课程,学生可以根据自己的兴趣和论文研究领域选择其中的许多课程。这些课程由洛克菲勒学院的教师组织,由校内外各领域的顶尖科学家讲授。学生可以根据自己的个人目标选择。
开设的核心专业课程包括:生化和生物物理方法Biochemical and Biophysical Methods、生物信息学Bioinformatics、细胞生物学Cell Biology、核过程细胞生物学Cell Biology of Nuclear Processes、细胞周期控制Cell Cycle Control、细胞神经生理学Cellular Neurophysiology、细胞与有机体代谢Cellular and Organismal Metabolism、化学生物学Chemical Biology、现代生物学的实验与理论Experiment and Theory in Modern Biology、基础免疫学和微生物学 Fundamental Immunology and Microbiology、用于生物和生物物理研究的光学和光学显微镜基础知识Fundamentals of Optics and Optical Microscopy for Biological and Biophysical Studies、遗传学与进化Genetics and Evolution、生命科学编程入门Introduction to Programming for the Life Sciences、哺乳动物遗传学Mammalian Genetics、数学建模Mathematical Modeling、微生物致病机理Microbial Pathogenesis、癌症的分子基础Molecular Basis of Cancer、社会进化与行为Social Evolution and Behavior、组织形态发生和癌症中的干细胞Stem Cells in Tissue Morphogenesis and Cancer、系统神经科学Systems Neuroscience、病毒学Virology。

戴维洛克菲勒生物科学研究生项目的教育和培训,为生物医学家打开了通往各种职业的大门。除了学术研究,学生和博士后还普遍对生物技术和制药业、科学教学和教育、技术转让和知识产权、管理咨询、科学写作和出版,以及科学政策和外交等领域的研究和非研究工作感兴趣。
在洛克菲勒大学,助理院长兼职业与专业发展主任Andrea Morris博士,帮助学员探索各种选择,获得从事所选职业所需的技能。鼓励学生和博士后在校期间寻求个人化的职业发展建议,参加职业发展研讨会、课程和活动,以探索职业生涯并为成功求职做好准备。

洛克菲勒大学生物科学研究生常规申请要求:
●申请截止时间:12月1日。
●学历和背景要求:大学招收对科学有天然好奇心、有能力、有热情并致力于研究的学生。攻读博士学位的学生,必须已获得文科或理科学士或硕士学位,或医学博士学位或同等国际资格。申请者必须在生物、化学、数学或物理科学领域取得较高成就。
●语言成绩要求:不要求提供GRE和托福成绩,也不会将其作为录取程序的一部分进行审查。
●申请文书及材料:
Statement of Purpose:由以下三部分组成,分别为:
(1)描述您迄今为止最有意义的研究经历。我们感兴趣的是您提出了什么重大问题,您是如何设计实验来回答这个问题的,以及您的研究结果告诉了您什么科学问题。请简要讨论如果您要继续研究这个问题,下一步会怎么做。评估申请的教师来自各个领域,因此请务必将重点放在高层次的科学概念上,而不仅仅是您所使用的具体技术。(限750字)
(2)请说明您希望在研究生院学习的科学领域,以及您的兴趣如何与洛克菲勒博士项目和洛克菲勒教师的研究相适应。请指明您感兴趣的洛克菲勒教员的研究方向。(限250字以内)(3)洛克菲勒大学的使命“科学造福人类”是我们大学文化和社区的核心。为了与这一使命保持一致,我们寻求能体现人类广泛经验的学生群体。请描述您的背景和经历将如何为洛克菲勒社区做出贡献,包括您在学术追求中必须克服的任何逆境。(限250字以内)
Letters of Recommendation:三至四位能够评估申请人研究潜力的赞助人的推荐信。
Transcripts:需要提交申请人所就读的每所学院或大学的正式成绩单,并填写在申请表的教育信息部分。作为在线申请的一部分,还必须扫描并上传每份正式成绩单的副本。


欢迎阅读我最新分享的欧美教育、科研、科技资讯:
